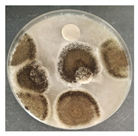
Micro 04 00008 i016
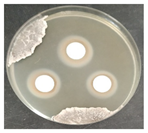
Micro 04 00008 i018
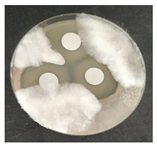
Micro 04 00008 i025

The Decorated Garden Grotto of Condes de Basto Palace in Évora, Portugal: Microbial Community Characterization and Biocide Tests for Conservation
Abstract
1. Introduction
2. Materials and Methods
2.1. Sampling Process
2.2. Detection of Microbiological Contamination
2.3. Characterization of Microbiota through Next Generation Sequencing (NGS)
2.4. Evaluation of Antimicrobial Activity
3. Results and Discussion
3.1. Detection of Microbial Contamination
3.2. Phylogenetic Metagenomic Approach
3.2.1. Eukaryote Communities
3.2.2. Prokaryote Communities
3.3. Evaluation of Antimicrobial Activity
4. Conclusions
Author Contributions
Funding
Institutional Review Board Statement
Informed Consent Statement
Data Availability Statement
Conflicts of Interest
References
- Rosado, T.; Silva, M.; Dias, L.; Candeias, A.; Gil, M.; Mirão, J.; Pestana, J.; Caldeira, A.T. Microorganisms and the Integrated Conservation-Intervention Process of the Renaissance Mural Paintings from Casas Pintadas in Évora—Know to Act, Act to Preserve Tânia. J. King Saud Univ.—Sci. 2017, 29, 478–486. [Google Scholar] [CrossRef]
- Joseph, E. (Ed.) Microorganisms in the Deterioration and Preservation of Cultural Heritage; Springer: Berlin/Heidelberg, Germany, 2021; ISBN 9783030694104. [Google Scholar]
- Dakal, T.C.; Cameotra, S.S. Microbially Induced Deterioration of Architectural Heritages: Routes and Mechanisms Involved. Environ. Sci. Eur. 2012, 24, 1–13. [Google Scholar] [CrossRef]
- Gaylarde, C. Influence of Environment on Microbial Colonization of Historic Stone Buildings with Emphasis on Cyanobacteria. Heritage 2020, 3, 1469–1482. [Google Scholar] [CrossRef]
- Warscheid, T.; Braams, J. Biodeterioration of Stone: A Review. Int. Biodeterior. Biodegrad. 2000, 46, 343–368. [Google Scholar] [CrossRef]
- Zhang, G.; Gong, C.; Gu, J.; Katayama, Y.; Someya, T.; Gu, J.D. Biochemical Reactions and Mechanisms Involved in the Biodeterioration of Stone World Cultural Heritage under the Tropical Climate Conditions. Int. Biodeterior. Biodegrad. 2019, 143, 104723. [Google Scholar] [CrossRef]
- Milanesi, C.; Baldi, F.; Vignani, R.; Ciampolini, F.; Faleri, C.; Cresti, M. Fungal Deterioration of Medieval Wall Fresco Determined by Analysing Small Fragments Containing Copper. Int. Biodeterior. Biodegrad. 2006, 57, 7–13. [Google Scholar] [CrossRef]
- Tyagi, P.; Verma, R.K.; Jain, N. Fungal Degradation of Cultural Heritage Monuments and Management Options. Curr. Sci. 2021, 121, 1553–1560. [Google Scholar] [CrossRef]
- Zucconi, L.; Canini, F.; Isola, D.; Caneva, G. Fungi Affecting Wall Paintings of Historical Value: A Worldwide Meta-Analysis of Their Detected Diversity. Appl. Sci. 2022, 12, 2988. [Google Scholar] [CrossRef]
- Trovão, J.; Portugal, A. Current Knowledge on the Fungal Degradation Abilities Profiled through Biodeteriorative Plate Essays. Appl. Sci. 2021, 11, 4196. [Google Scholar] [CrossRef]
- Rosado, T.; Dias, L.; Lança, M.; Nogueira, C.; Santos, R.; Martins, M.R.; Candeias, A.; Mirão, J.; Caldeira, A.T. Assessment of Microbiota Present on a Portuguese Historical Stone Convent Using High-Throughput Sequencing Approaches. MicrobiologyOpen 2020, 9, 1067–1084. [Google Scholar] [CrossRef]
- Lourenço e Silva, A. Conservação e Restauro de Embrechados. In Proceedings of the Conservação e Restauro de Artes Decorativas de Aplicação Arquitectónica, Porto, Portugal, 29 September 2012; p. 167. [Google Scholar]
- Da Silva, M.T.C. Novel Biocides for Cultural Heritage; Universidade de Évora: Évora, Portugal, 2017. [Google Scholar]
- Salvador, C.; Silva, M.; Rosado, T.; Freire, R.V.; Bordalo, R.; Candeias, A.; Caldeira, A.T. Biodeterioração de Pinturas de Cavalete: Desenvolvimento de Novas Estratégias de Mitigação. Conserv. Património 2016, 23, 119–124. [Google Scholar] [CrossRef]
- Schoch, C.L.; Sung, G.H.; López-Giráldez, F.; Townsend, J.P.; Miadlikowska, J.; Hofstetter, V.; Robbertse, B.; Matheny, P.B.; Kauff, F.; Wang, Z.; et al. The Ascomycota Tree of Life: A Phylum-Wide Phylogeny Clarifies the Origin and Evolution of Fundamental Reproductive and Ecological Traits. Syst. Biol. 2009, 58, 224–239. [Google Scholar] [CrossRef]
- Văcar, C.L.; Mircea, C.; Pârvu, M.; Podar, D. Diversity and Metabolic Activity of Fungi Causing Biodeterioration of Canvas Paintings. J. Fungi 2022, 8, 589. [Google Scholar] [CrossRef]
- Li, Q.; Zhang, B.; He, Z.; Yang, X. Distribution and Diversity of Bacteria and Fungi Colonization in Stone Monuments Analyzed by High-Throughput Sequencing. PLoS ONE 2016, 11, e0163287. [Google Scholar] [CrossRef] [PubMed]
- Sanders, W.B.; Masumoto, H. Lichen Algae: The Photosynthetic Partners in Lichen Symbioses. Lichenologist 2021, 53, 347–393. [Google Scholar] [CrossRef]
- Grimm, M.; Grube, M.; Schiefelbein, U.; Zühlke, D.; Bernhardt, J.; Riedel, K. The Lichens’ Microbiota, Still a Mystery? Front. Microbiol. 2021, 12, 623839. [Google Scholar] [CrossRef]
- Bungartz, F.; Søchting, U.; Arup, U. Teloschistaceae (Lichenized Ascomycota) from the Galapagos Islands: A Phylogenetic Revision Based on Morphological, Anatomical, Chemical, and Molecular Data. Plant Fungal Syst. 2020, 65, 515–576. [Google Scholar] [CrossRef]
- Caneva, G.; Fidanza, M.R.; Tonon, C.; Favero-Longo, S.E. Biodeterioration Patterns and Their Interpretation for Potential Applications to Stone Conservation: A Hypothesis from Allelopathic Inhibitory Effects of Lichens on the Caestia Pyramid (Rome). Sustainability 2020, 12, 1132. [Google Scholar] [CrossRef]
- Cámara, B.; De Buergo, M.Á.; Fort, R.; Souza-Egipsy, V.; Perez-Ortega, S.; De Los Ríos, A.; Wierzchos, J.; Ascaso, C. Anthropic Effect on the Lichen Colonization in Building Stones from Cultural Heritage. Period. Di Mineral. 2015, 84, 539–552. [Google Scholar] [CrossRef]
- Carter, N.E.A.; Viles, H.A. Lichen Hotspots: Raised Rock Temperatures beneath Verrucaria Nigrescens on Limestone. Geomorphology 2004, 62, 1–16. [Google Scholar] [CrossRef]
- Kamyabi, A.S.; Iranbakhsh, A.; Moniri, M.H.; Asri, Y. New Records of Five Verrucaria Species (Verrucariacaea, Ascomycota) from Iran. Feddes Repert. 2023, 134, 191–199. [Google Scholar] [CrossRef]
- Pinna, D.; Galeotti, M.; Perito, B.; Daly, G.; Salvadori, B. In Situ Long-Term Monitoring of Recolonization by Fungi and Lichens after Innovative and Traditional Conservative Treatments of Archaeological Stones in Fiesole (Italy). Int. Biodeterior. Biodegrad. 2018, 132, 49–58. [Google Scholar] [CrossRef]
- Morando, M.; Matteucci, E.; Nascimbene, J.; Borghi, A.; Piervittori, R.; Favero-Longo, S.E. Effectiveness of Aerobiological Dispersal and Microenvironmental Requirements Together Influence Spatial Colonization Patterns of Lichen Species on the Stone Cultural Heritage. Sci. Total Environ. 2019, 685, 1066–1074. [Google Scholar] [CrossRef] [PubMed]
- Tonon, C.; Favero-Longo, S.E.; Matteucci, E.; Piervittori, R.; Croveri, P.; Appolonia, L.; Meirano, V.; Serino, M.; Elia, D. Microenvironmental Features Drive the Distribution of Lichens in the House of the Ancient Hunt, Pompeii, Italy. Int. Biodeterior. Biodegrad. 2019, 136, 71–81. [Google Scholar] [CrossRef]
- Favero-Longo, S.E.; Castelli, D.; Fubini, B.; Piervittori, R. Lichens on Asbestos-Cement Roofs: Bioweathering and Biocovering Effects. J. Hazard. Mater. 2009, 162, 1300–1308. [Google Scholar] [CrossRef]
- Nascimbene, J.; Salvadori, O. Lichen Recolonization on Restored Calcareous Statues of Three Venetian Villas. Int. Biodeterior. Biodegrad. 2008, 62, 313–318. [Google Scholar] [CrossRef]
- Altieri, A.; Pietrini, M.; Ricci, S.; Roccardi, A.; Piervittori, R. The Temples of the Archaeological Area of Paestum (Italy): A Case Study on Biodeterioration. In Proceedings of the 9th International Congress on Deterioration and Conservation of Stone, Venice, Italy, 19–24 June 2000; Fassina, V., Ed.; Elsevier Science B.V.: Amsterdam, The Netherlands, 2000; pp. 433–443, ISBN 9780444505170. [Google Scholar]
- de los Ríos, A.; Cámara, B.; García del Cura, M.Á.; Rico, V.J.; Galván, V.; Ascaso, C. Deteriorating Effects of Lichen and Microbial Colonization of Carbonate Building Rocks in the Romanesque Churches of Segovia (Spain). Sci. Total Environ. 2009, 407, 1123–1134. [Google Scholar] [CrossRef] [PubMed]
- Li, Q.; Zhang, B.; Yang, X.; Ge, Q. Deterioration-Associated Microbiome of Stone Monuments: Structure, Variation, and Assembly. Appl. Environ. Microbiol. 2018, 84, 1–19. [Google Scholar] [CrossRef]
- Kosecka, M.; Kukwa, M.; Jabłońska, A.; Flakus, A.; Rodriguez-Flakus, P.; Ptach, L.; Guzow-Krzemińska, B. Phylogeny and Ecology of Trebouxia Photobionts From Bolivian Lichens. Front. Microbiol. 2022, 13, 779784. [Google Scholar] [CrossRef] [PubMed]
- Kroken, S.; Taylor, J.W. Phylogenetic Species, Reproductive Mode, and Specificity of the Green Alga Trebouxia Forming Lichens with the Fungal Genus Letharia. Bryologist 2000, 103, 645–660. [Google Scholar] [CrossRef]
- Ding, X.; Lan, W.; Yan, A.; Li, Y.; Katayama, Y.; Gu, J.D. Microbiome Characteristics and the Key Biochemical Reactions Identified on Stone World Cultural Heritage under Different Climate Conditions. J. Environ. Manag. 2022, 302, 114041. [Google Scholar] [CrossRef]
- Ding, Y.; Salvador, C.S.C.; Caldeira, A.T.; Angelini, E.; Schiavon, N. Biodegradation and Microbial Contamination of Limestone Surfaces: An Experimental Study from Batalha Monastery, Portugal. Corros. Mater. Degrad. 2021, 2, 31–45. [Google Scholar] [CrossRef]
- Bates, S.T.; Cropsey, G.W.G.; Caporaso, J.G.; Knight, R.; Fierer, N. Bacterial Communities Associated with the Lichen Symbiosis. Appl. Environ. Microbiol. 2011, 77, 1309–1314. [Google Scholar] [CrossRef] [PubMed]
- Grube, M.; Cernava, T.; Soh, J.; Fuchs, S.; Aschenbrenner, I.; Lassek, C.; Wegner, U.; Becher, D.; Riedel, K.; Sensen, C.W.; et al. Exploring Functional Contexts of Symbiotic Sustain within Lichen-Associated Bacteria by Comparative Omics. ISME J. 2015, 9, 412–424. [Google Scholar] [CrossRef] [PubMed]
- Grube, M.; Wedin, M. Lichenized Fungi and the Evolution of Symbiotic Organization. Microbiol. Spectr. 2016, 4, 749–765. [Google Scholar] [CrossRef] [PubMed]
- Kelly, D.P.; McDonald, I.R.; Wood, A.P. The Family Mehylobacteriaceae. In The Prokaryotes: Alphaproteobacteria and Betaproteobacteria; Rosenberg, E., DeLong, E.F., Lory, S., Stackebrandt, E., Thompson, F., Eds.; Springer: Berlin/Heidelberg, Germany, 2014; pp. 313–340. ISBN 9783642301971. [Google Scholar]
- Xu, F.F.; Morohoshi, T.; Wang, W.Z.; Yamaguchi, Y.; Liang, Y.; Ikeda, T. Evaluation of Intraspecies Interactions in Biofilm Formation by Methylobacterium Species Isolated from Pink-Pigmented Household Biofilms. Microbes Environ. 2014, 29, 388–392. [Google Scholar] [CrossRef] [PubMed]
- Silva, N.C.; Madureira, A.R.; Pintado, M.; Moreira, P.R. Biocontamination and Diversity of Epilithic Bacteria and Fungi Colonising Outdoor Stone and Mortar Sculptures. Appl. Microbiol. Biotechnol. 2022, 106, 3811–3828. [Google Scholar] [CrossRef] [PubMed]
- Bjelland, T.; Grube, M.; Hoem, S.; Jorgensen, S.L.; Daae, F.L.; Thorseth, I.H.; Øvreås, L. Microbial Metacommunities in the Lichen-Rock Habitat. Environ. Microbiol. Rep. 2011, 3, 434–442. [Google Scholar] [CrossRef]
- Egas, C.; Barroso, C.; Froufe, H.J.C.; Pacheco, J.; Albuquerque, L.; da Costa, M.S. Complete Genome Sequence of the Radiation-Resistant Bacterium Rubrobacter Radiotolerans RSPS-4. Stand. Genom. Sci. 2015, 9, 1062–1075. [Google Scholar] [CrossRef]
- Schabereiter-Gurtner, C.; Piñar, G.; Vybiral, D.; Lubitz, W.; Rölleke, S. Rubrobacter-Related Bacteria Associated with Rosy Discolouration of Masonry and Lime Wall Paintings. Arch. Microbiol. 2001, 176, 347–354. [Google Scholar] [CrossRef]
- Ettenauer, J.D.; Jurado, V.; Piñar, G.; Miller, A.Z.; Santner, M.; Saiz-Jimenez, C.; Sterflinger, K. Halophilic Microorganisms Are Responsible for the Rosy Discolouration of Saline Environments in Three Historical Buildings with Mural Paintings. PLoS ONE 2014, 9, e103844. [Google Scholar] [CrossRef] [PubMed]
- Kusumi, A.; Li, X.; Osuga, Y.; Kawashima, A.; Gu, J.D.; Nasu, M.; Katayama, Y. Bacterial Communities in Pigmented Biofilms Formed on the Sandstone Bas-Relief Walls of the Bayon Temple, Angkor Thom, Cambodia. Microbes Environ. 2013, 28, 422–431. [Google Scholar] [CrossRef] [PubMed]







| Sample Code | Lichens Observation | LEICA M205C |
|---|---|---|
| B2 | ![]() | ![]() |
| B3 | ![]() | ![]() |
| B4 | ![]() | ![]() |
| B6 | ![]() | ![]() |
| B8 | ![]() | ![]() |
| Name | Sampling Zone | Control | Preventol® Ri 50 | Biotin-T |
|---|---|---|---|---|
| Z1 | ![]() | ![]() | ![]() | ![]() |
| Z3 | ![]() | ![]() | ![]() | ![]() |
| Z4 | ![]() | ![]() | ![]() | ![]() |
| Z7 | ![]() | ![]() | ![]() | ![]() |
| Sampling Zone | Inhibition Halos (mm) | |
|---|---|---|
| Preventol ® Ri 50 | Biotin-T | |
| Z1 | 32.0 ± 5.0 | ti 1 |
| Z3 | 12.0 ± 1.0 | 47.0 ± 3.0 |
| Z4 | 26.0 ± 4.0 | 35.0 ± 1.0 |
| Z7 | 4.0 ± 2.0 | 27.0 ± 1.0 |
Disclaimer/Publisher’s Note: The statements, opinions and data contained in all publications are solely those of the individual author(s) and contributor(s) and not of MDPI and/or the editor(s). MDPI and/or the editor(s) disclaim responsibility for any injury to people or property resulting from any ideas, methods, instructions or products referred to in the content. |
© 2024 by the authors. Licensee MDPI, Basel, Switzerland. This article is an open access article distributed under the terms and conditions of the Creative Commons Attribution (CC BY) license (https://creativecommons.org/licenses/by/4.0/).
Share and Cite
Silva, I.; Salvador, C.; Arantes, S.; Miller, A.Z.; Candeias, A.; Caldeira, A.T. The Decorated Garden Grotto of Condes de Basto Palace in Évora, Portugal: Microbial Community Characterization and Biocide Tests for Conservation. Micro 2024, 4, 117-131. https://doi.org/10.3390/micro4010008
Silva I, Salvador C, Arantes S, Miller AZ, Candeias A, Caldeira AT. The Decorated Garden Grotto of Condes de Basto Palace in Évora, Portugal: Microbial Community Characterization and Biocide Tests for Conservation. Micro. 2024; 4(1):117-131. https://doi.org/10.3390/micro4010008
Chicago/Turabian StyleSilva, Inês, Cátia Salvador, Sílvia Arantes, Ana Z. Miller, António Candeias, and Ana Teresa Caldeira. 2024. "The Decorated Garden Grotto of Condes de Basto Palace in Évora, Portugal: Microbial Community Characterization and Biocide Tests for Conservation" Micro 4, no. 1: 117-131. https://doi.org/10.3390/micro4010008
APA StyleSilva, I., Salvador, C., Arantes, S., Miller, A. Z., Candeias, A., & Caldeira, A. T. (2024). The Decorated Garden Grotto of Condes de Basto Palace in Évora, Portugal: Microbial Community Characterization and Biocide Tests for Conservation. Micro, 4(1), 117-131. https://doi.org/10.3390/micro4010008